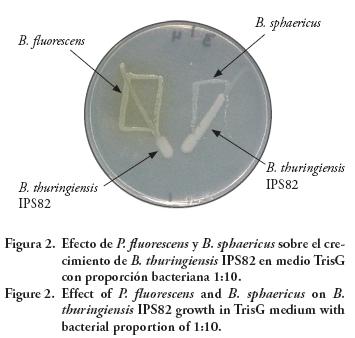

Servicios Personalizados
Revista
Articulo
Indicadores
-
 Citado por SciELO
Citado por SciELO -
 Accesos
Accesos
Links relacionados
-
 Similares en
SciELO
Similares en
SciELO
Compartir
Agrociencia
versión On-line ISSN 2521-9766versión impresa ISSN 1405-3195
Agrociencia vol.44 no.8 Texcoco nov./dic. 2010
Protección vegetal
Análisis poblacional de células vegetativas de Bacillus thuringiensis en interacción in vitro con bacterias del suelo
Population analysis of Bacillus thuringiensis interaction in vitro with soil bacteria
Norma E. Rojas–Ruiz*, Candelario Vázquez–Cruz*, Patricia Sánchez–Alonso, Estibaliz Sansinenea–Royano
Centro de Investigaciones en Ciencias Microbiológicas, Instituto de Ciencias, Benemérita Universidad Autónoma de Puebla. 72570. Puebla, Puebla, México. *Autor responsable: (normaelena_rojas @yahoo.com.mx).
Recibido: Agosto, 2009.
Aprobado: Octubre, 2010.
Resumen
La bacteria Bacillus thuringiensis se usa como bioinsecticida agrícola, pero se conoce poco sobre su persistencia en el suelo. El objetivo de este trabajo fue analizar la interacción de las células vegetativas o no esporuladas de B. thuringiensis, con 11 microorganismos nativos de suelo. Las bacterias fueron confrontadas por cocultivo de pares en condiciones controladas, y se evaluaron cinéticas de crecimiento por conteo celular en placa de los microorganismos estudiados. Los resultados mostraron que el desarrollo de B. thuringiensis es afectado por siete de los 11 microorganismos de suelo evaluados. De estos antagonistas, Pseudomonas fluorescens fue uno de los que redujeron más la población de células vegetativas de B. thuringiensis, a 28 °C versus 37 °C; esto sugiere un posible mecanismo de termorregulación del antagonismo. El efecto antagónico de P. fluorescens también se observó sobre otros B. thuringiensis del suelo, aislados en este trabajo, incluso en medio libre de células de P. fluorescens, lo que indica susceptibilidad de B. thuringiensis a las substancias antibacterianas de P. fluorescens. Esto sugiere que el suelo es un ambiente poco apropiado para la multiplicación celular de B. thuringiensis por un posible antagonismo microbiano.
Palabras clave: Antagonismo microbiano, Pseudomonas fluorescens, Klebsiella pneumoniae.
Abstract
The bacteria Bacillus thuringiensis is used as a biological insecticide in agriculture, but little is known about its persistence in the soil. The objective of this study was to analyze the interaction of the vegetative, or non–sporulated, cells of B. thuringiensis, with 11 native soil microorganisms. The bacteria were confronted by paired co–culture under controlled conditions, and growth kinetics of the studied microorganisms was evaluated by cell count on plates. The results showed that the development of B. thuringiensis is affected by seven of the 11 soil microorganisms. Of these antagonists, Pseudomonas fluorescens was one of those that most reduced the population of B. thuringiensis vegetative cells at 28 °C but not at 37 °C. This suggests a possible mechanism of thermoregulation in the antagonism. The antagonistic effect of P. fluorescens was also observed on other soil B. thuringiensis strains isolated during this study, even in medium that was free of P. fluorescens cells, indicating B. thuringiensis susceptibility to antibacterial substances of P. fluorescens. This suggests that the soil is not an environment that favors the multiplication of B. thuringiensis cells because of possible microbial antagonism.
Key words: Microbial antagonism, Pseudomonas fluorescens, Klebsiella pneumoniae.
INTRODUCCIÓN
Bacillus thuringiensis es uno de los agentes de control biológico más exitosos, porque posee una especificidad alta contra insectos plaga o vectores de enfermedades (Meadows, 1993; Aguilar e Ibarra, 1995). El principal factor de patogenicidad de esta bacteria es la proteína Cry específica, que altera la integridad del intestino de los insectos (Crickmore et al., 1998; De Maagd et al., 2001). Debido a la capacidad infectiva específica, B. thuringiensis se considera un entomopatógeno, aunque también se ha considerado un microorganismo nativo de suelo, porque se puede aislar frecuentemente de muestras de este hábitat (Martin y Phillis, 1994). Sin embargo, la información de la persistencia de B. thuringiensis es poco clara por la complejidad del sistema suelo y porque con frecuencia se hace el monitoreo de células esporuladas o inactivas metabólicamente. Estas células no permiten observar condiciones favorables de crecimiento, ni las desfavorables como la carencia de nutrientes específicos o el antagonismo microbiano. La situación es aún mas controvertida cuando se pretende estudiar la supervivencia de B. thuringiensis introduciendo esporas en el suelo (Petras y Casida, 1985; West et al., 1985). El objetivo del presente estudio fue analizar las fluctuaciones poblacionales de B. thuringiensis cuando interactúa como célula vegetativa con otros microorganismos nativos del suelo y determinar la posible relación benéfica o antagónica entre estos microorganismos. Lo cual nos permitiría conocer mejor las condiciones fisiológicas microbianas que existen en el suelo y que rigen la desaparición de los microorganismos considerados bioinsecticidas del tipo B. thuringiensis.
MATERIALES Y MÉTODOS
Material biológico
Se utilizaron cepas de B. thuringiensis de referencia, con actividad bioinsecticida, y varios aislados de B. thuringiensis y B. cereus del ambiente (Cuadro 1). Estas cepas fueron confrontadas con las bacterias señaladas en el Cuadro 2, con el fin de determinar el tipo de convivencia (mutualismo o antagonismo) entre ellas.
Medios de cultivo
Se usaron cuatro medios de cultivo (Cuadro 3). Los medios DSM y TrisG favorecen la esporulación de B. thuringiensis y GGM la inhibe. El medio LB se usó para el cultivo de todas las bacterias y para evaluar la resistencia a cloranfenicol. La determinación de la resistencia a cloranfenicol fue necesaria para facilitar el conteo celular en las cinéticas de cocultivo en líquido, para esto se usaron diluciones seriadas del antibiótico (de 10 a 0.3 μg mL–1), con lo que se determinó la concentración de antibiótico que resiste cada cepa bacteriana y que es apropiada para la selección bacteriana según se requiriera en los ensayos de confrontación.
Confrontación de B. thuringiensis con bacterias del suelo
La relación biológica entre B. thuringiensis y los microorganismos de suelo (Cuadro 2) fue evaluada cualitativamente. Se prepararon cultivos en suspensión de todas las bacterias con 5 mL de caldo LB, incubándolos a 28 °C con agitación constante a 200 revoluciones por minuto (rpm) durante 8 h, para alcanzar una densidad celular aproximada de 1 X106 unidades formadoras de colonias (UFC) por mililitro. De los cultivos en suspensión se prepararon diluciones para sembrar cajas Petri en ensayos de confrontación bacteriana por pares. Las bacterias retadoras se sembraron con asa de manera rectangular (Figura 1) en los medios TrisG, DSM y GGM. La suspensión de B. thuringiensis se inoculó atravesando el rectángulo, en forma de línea diagonal para crear un gradiente poblacional en la estría simple. Las diluciones se usaron para crear pruebas de "rectángulos cruzados" con tres proporciones de poblaciones bacterianas 2:1, 1:1 y 1:10 de B. thuringiensis vs la cepa retadora respectivamente (modificaciones de Cafferkey et al., 1989; Sibide et al., 1993). Las cajas sembradas se incubaron a 28 °C por 14 h y se registró el tipo de inhibición de crecimiento de B. thuringiensis.

Análisis de la difusión del antibacteriano de P. fluorescens y susceptibilidad de B. thuringiensis
Para determinar si el efecto antagónico de P. fluorescens es general contra B. thuringiensis, o si está restringido a las bacterias de las cepas de productos comerciales como HD1, HD73 o IPS82, el ensayo de confrontación se amplió con mayor número de cepas de Bacilli en un sistema de difusión de tóxicos en placa. Para ello, se sembraron homogéneamente 1X10 ylXIO UFC de P. fluorescens, en medio TrisG sólido que tenía cubierta la superficie con una membrana estéril de celofán dulce. Estas cajas se incubaron durante 12 h a 28 °C, y se retiró el celofán junto con las bacterias. Las placas inoculadas nuevamente en la superficie libre de colonias con 1X10 UFC de células vegetativas de las cepas de B. thuringiensis y B. cereus (Cuadro 1) para determinar su capacidad de crecimiento.
Efecto del cultivo mixto de B. thuringiensis y P. fluorescens en medio líquido
Debido a que los medios sólidos presentan dificultad para observar la interacción celular, por la falta de movilidad celular, y que sólo aportan información cualitativa, se prepararon cultivos líquidos en los que se inocularon cantidades conocidas de células vegetativas y se monitoreó la fluctuación poblacional, como un indicador de la relación biológica de bacterias potencialmente antagónicas. Para ello, se cultivaron por separado las cepas B. thuringiensis HD73, HD1, IPS82 y NRB34 y P. fluorescens en medio TrisG por 10 h a 28 °C con agitación constante. En matraces de 250 mL se sembraron mezclas de bacterias en proporciones 1:1 y 10:1 de B. thuringiensis vs P. fluorescens respectivamente, en un volumen final de 30 mL. Los cultivos mixtos se incubaron a 28 °C con agitación constante a 200 rpm. Cada hora se tomaron muestras y se hicieron diluciones seriadas (10–1 a 10–6) para sembrarlas en placas de LB por el método de gota, y determinar las UFC sobrevivientes de B. thuringiensis respecto al tiempo de interacción homogénea en medio líquido. El recuento de la población de P. fluorescens se efectuó en medio LB adicionado de 5 μgde cloranfenicol. La población de B. thuringiensis fue determinada por la morfología cerosa de las colonias en medio sin antibiótico. La incubación de las mezclas bacterianas por 24 h se efectuó con el fin de determinar si B. thuringiensis esporulaba y la proporción de células esporuladas de la población total en la condición de cocultivo.
Evaluación del extracto de P. fluorescens en el crecimiento de B. thuringiensis
Se prepararon extractos líquidos libres de células antagónicas para establecer si las bacterias más antagónicas a B. thuringiensis liberaban substancias tóxicas y si éstas se acumulaban. La bacteria P. fluorescens se cultivó en medio TrisG líquido por 12 h con agitación a 28 °C. La suspensión bacteriana se centrifugó a 12 000 rpm y el sobrenadante se filtró con membranas Millipore* con diámetro de poro de 0.45 μm. El extracto libre de P. fluorescens se agregó al medio TrisG líquido nuevo en las proporciones: 1:1, 3:1 y 1:3, para tener una evaluación cualitativa de la inhibición de crecimiento. En estas mezclas se sembró B. thuringiensis y como control se cultivó a B. thuringiensis en medio TrisG nuevo y mezclado con medio TrisG libre de B. thuringiensis. El ensayo fue efectuado en matraces de 250 mL que contenían 30 mL de cada una de las mezclas que se inocularon con aproximadamente 5X105 UFC de células vegetativas de B. thuringiensis. Los matraces se incubaron a 28 °C con agitación constante; debido a que en la proporción 1:1 con inoculo de 1X106 UFC de B. thuringiensis se registró crecimiento, se efectuó la cuantificación de las UFC de las cepas IPS82, 45IV, 51II, 65IVy 71I en la mezcla 1:1 para fines comparativos de supervivencia. Cada hora se tomaron muestras de 1 mL para hacer diluciones seriadas (10–1 a 10–6) y sembrarlas en placas de LB por el método de gota. Así se contó el número de UFC sobrevivientes de B. thuringiensis respecto al tiempo de tratamiento con extractos bacterianos libres de células antagónicas.
RESULTADOS Y DISCUSIÓN
Establecimiento de condiciones para los ensayos de confrontación bacteriana
Las cepas de B. thuringiensis crecieron cuando se cultivaron en medio TrisG a 28 °C. En esta condición el tiempo de generación fue de 20 min para las cepas HD73, HD1 e IPS82. De estas tres cepas, la IPS82 mostró tiempos de incubación mayores para esporular, por esta característica la cepa fue elegida para llevar a cabo la mayor parte de los experimentos de confrontación bacteriana, porque con ella se aseguraba el estado vegetativo de B. thuringiensis. También se determinó la resistencia bacteriana a cloranfenicol, que es de 5 μgmL en P. fluorescens, B. cereus, S. marcescens, B. cepacia, y en las cepas NR1, NR3, NR4, NR6. La resistencia es de 1 μgmL–1, en B. sphaericus y K. pneumoniae. Mientras que las cepas HD1, HD73, IPS82, 45IV, 5HI, 65IV, 711, NR2 y NR5, escasamente resistieron 0.5 μgL–1. El fenotipo de resistencia en P. fluorescens se usó para el recuento celular en placa durante las cinéticas de crecimiento microbiano, en tanto que para B. thuringiensis fue suficiente usar la morfología colonial cerosa característica para su conteo.
Análisis de la confrontación de B. thuringiensis con bacterias de suelo
Las condiciones de cultivo descritas en este trabajo favorecen el crecimiento de B. thuringiensis, por lo que las interacciones B. thuringiensis con cualquier bacteria habitante del suelo, en un modelo de reto por pares, podrían ser benéficas o antagónicas en dependencia de la abundancia del crecimiento en placas de Petri con los medios sólidos propuestos. Para la prueba de confrontación cualitativa se diseñó un experimento de rectángulo cruzado (Figura 1) porque el antagonismo se observó mejor que al hacer una sola intersección de estrías en siete de 11 cepas probadas contra B. thuringiensis. Se observaron varios tipos de crecimiento en el sembrado de modelo de rectángulo cruzado (Cuadro 4) los cuales fueron desde la inhibición de B. thuringiensis en la primera zona de interacción con las bacterias de suelo hasta la ausencia de inhibición a lo largo de la estría.
El fenómeno de antagonismo hacia B. thuringiensis fue más claro con el uso de tres medios de cultivo, porque en función de éste se afecta su manifestación. Lo anterior se debe, probablemente a la composición nutricional del medio y su relación con la expresión de funciones de competitividad metabólica. Como una aproximación a los diferentes ambientes donde puede variar la población de microorganismos, también se usaron varias proporciones bacterianas en los ensayos de confrontación. Así, se observó que el antagonismo es más marcado cuando existe una población menor de B. thuringiensis respecto a otras bacterias, entre ellas las del género Pseudomonas (proporción 1:10; Figura 2).
La clase de interacción de B. cereus con B. thuringiensis no fue observada, porque la morfología colonial de ambos es similar. El crecimiento de B. cepacia fue insuficiente en los tres medios de cultivo empleados, por lo que no se presentan estos resultados. Las bacterias con mayor desarrollo mostraron antagonismo contra B. thuringiensis, con excepción de las cepas NR2, NR5 y NR6. En el medio DSM la inhibición antagónica se observó en cualquier proporción de microorganismos, mientras que este efecto fue notorio sobre el medio GGM en las proporciones 1:1 y 1:10. En los experimentos de interacción bacteriana destaca el antagonismo de P. fluorescens sobre B. thuringiensis, pues la inhibición del crecimiento es evidente desde la primera interacción de las estrías, igual que con las cepas pigmentadas de verde NR1, NR3 y NR4 (Figura 2).
El efecto antagónico ejercido por bacterias pigmentadas de verde puede deberse a la producción de sustancias tóxicas para B. thuringiensis. Este es el caso de P. fluorescens, que produce antibióticos, como metabolitos secundarios, y cuya expresión está sujeta a termorregulación (Duffy y Défago, 1999; Budde y Ullrich, 2000). La inhibición de B. thuringiensis en presencia de P. fluorescens fue dependiente de la temperatura (Cuadro 5). La prueba del rectángulo cruzado con la proporción 1:1, en dos temperaturas de incubación (28 y 37 °C), mostró que la mayoría de las cepas redujeron el efecto antagónico contra B. thuringiensis a 37 °C respecto al producido a 28 °C. Inclusive a 37 °C se redujo o desapareció la pigmentación característica de P. fluorescens. Por tanto, la temperatura relativamente alta parece ser un factor que regula la supervivencia de B. thuringiensis.
Análisis de la difusión antibacteriana de P. fluorescens y susceptibilidad de B. thuringiensis
La susceptibilidad de varias cepas de B. thuringiensis a P. fluorescens resultó ser novedosa. Sin embargo, como los Bacilli y P. fluorescens son habitantes nativos de suelo, posiblemente existen Bacilli resistentes a P. fluorescens. También, podía haber interferencia a la difusión y alcance de las substancias producidas por P. fluorescens. El análisis en placa con celofán dulce mostró que las 48 cepas de B. thuringiensis evaluadas son resistentes a las substancias difusibles de color verde–amarillo que produjeron 1 X105 UFC de bacteria antagonista por placa, durante 12 h a 28 °C. Sin embargo, la resistencia no se mantuvo cuando se incrementó la cantidad de bacterias antagonistas sembradas en el celofán a 1X107 UFC, con excepción de la cepa NRB34, en esta condición se observó acumulación mayor de productos de color verdoso de P. fluorescens. Las substancias producidas que difunden a través del celofán podrían evaluarse en medios de cultivo libres de células o extractos enriquecidos con tóxicos de P. fluorescens, como se muestra más adelante.
Análisis del cultivo mixto de B. thuringiensis y P. fluorescens en medio líquido
Para abordar el aspecto cuantitativo de la interacción antagónica en cultivo líquido de B. thuringiensis con otro microorganismo se eligió a P. fluorescens, dado que presenta un fenotipo de resistencia a cloran–fenicol que contrasta con B. thuringiensis. Para esta prueba se analizaron las cepas B. thuringiensis, IPS82 y NRB34. La última se eligió porque el antagonismo cualitativo de P. fluorescens fue menor respecto a todo el grupo de Bacilli estudiado. La evaluación en medio líquido se llevó a cabo en condiciones intermedias de antagonismo, medio TrisG y proporción bacteriana (1:1). Aunque del análisis en medio sólido, se sabía que la proporción 1:10 era de antagonismo marcado, ésta se usó para la comparación de viabilidad de B. thuringiensis.
En la cinética de crecimiento en la mezcla 1:1 se observó tendencia de crecimiento de B. thuringiensis IPS82 hasta las 4 h, pero su crecimiento cesó con pérdida de la viabilidad a las 7 h (Figura 3). Para la cepa de P. fluorescens se observó desarrollo celular y la viabilidad se mantuvo a la séptima hora, aunque se observó que ese tiempo corresponde con el inicio de la fase estacionaria de crecimiento en el medio TrisG. La afectación de la viabilidad de B. thuringiensis, coincide con la fase estacionaria de crecimiento de P. fluorescens, la que se asocia con la producción de metabolitos secundarios. Entre estos están los clasificados como antibiótico y los de tipo bacteriocina (Nielsen et al., 1998; Parret y De Mot, 2002; Riley y Wertz, 2002; Rojas et al., 2005). La cepa NRB34 en el medio líquido mantuvo su población celular en la proporción 1:1 según el ensayo cualitativo en las placas de TrisG, incluso a las 11 h de contacto con P. fluorescens. La observación al microscopio de contraste de fases de los cultivos mixtos de la cepa IPS82 a las 11 h mostró destrucción celular. En tanto que la mezcla con la cepa NRB34 contenía esporas refringentes que se mantuvieron hasta por 24 h. Esta característica de diferenciación celular durante la confrontación podría explicar la ventaja competitiva de la cepa NRB34 respecto a IPS82. La condición de cultivo de la proporción 1:10 mostró que la cepa NRB34 de B. thuringiensis también muere, e indica que los Bacilli pueden ser sensibles a las substancias liberadas por P. fluorescens. Aunque, el efecto antagónico se observa claramente cuando la población de antagonistas es mayor respecto a B. thuringiensis y cuando el tiempo y las condiciones para que la bacteria no esporule.

Evaluación del efecto del extracto de P. fluorescens en el crecimiento de B. thuringiensis
En estudios previos se determinó que el efecto antagónico es independiente de la diferencia del tiempo de generación entre B. thuringiensis IPS82 y P. fluorescens, porque fue de 20 min para ambas bacterias. También, podría ser consecuencia de un proceso mediado por la liberación y acumulación de sustancias tóxicas al medio. Por lo que, se evaluó la presencia de posibles tóxicos liberados al medio de cultivo por P. fluorescens y que afectan a B. thuringiensis. Para ello, el medio libre de células de P. fluorescens fue mezclado con medio nuevo de cultivo TrisG en diversas proporciones y se observó la alteración del desarrollo de B. thuringiensis (Cuadro 6). Los resultados indican que el inoculo de 1 X105 UFC de B. thuringiensis IPS82 no sobrevivió en ninguna de las proporciones probadas. Mientras que, cuando se aumentó el inoculo a 1 X 106 UFC y disminuyó la cantidad de medio libre de células respecto al medio TrisG nuevo en las mezclas se observó desarrollo de B. thuringiensis IPS82. Estos resultados concuerdan con la hipótesis de que P. fluorescens libera tóxicos que se acumulan en el medio de cultivo y causan la muerte de B. thuringiensis.
También se analizó el efecto del extracto libre de células de P. fluorescens sobre otras cepas de B. thuringiensis de la colección con el objetivo de conocer la sensibilidad de B. thuringiensis IPS82 a los tóxicos del extracto. Los resultados de viabilidad indicaron susceptibilidad alta de los Bacilli probados en este ensayo, pues su población se disminuyó de 1 a 3 órdenes de magnitud en un lapso de 8 h (Figura 4). Con base en estos resultados se puede deducir que como consecuencia de la liberación y acumulación de substancias tóxicas las células vegetativas de B. thuringiensis pueden desaparecer, incluso en ausencia temporal de bacterias antagónicas en el ambiente. Los resultados confirman lo documentado en la literatura, respecto a que metabolitos secundarios involucrados en interacciones antagonistas pueden afectar el crecimiento y actividades de competidores para beneficio de sus productores (Firn y Jones, 2000; Notz et al., 2002; Validov et al., 2005; Karlovsky, 2008).

CONCLUSIONES
En los ensayos de confrontación cualitativa mostraron que 64% de los microorganismos evaluados ejercen efecto antagónico sobre cepas de B. thuringiensis empleadas como bioinsecticidas. Las bacterias de suelo que exhibieron claramente este fenómeno fueron: P. fluorescens, K. pneumoniae, B. sphaericus y S. marcescens. Se demostró la susceptibilidad de B. thuringiensis a la interacción con otros microorganismos metabólicamente activos del suelo. Se propone que el antagonismo ejercido por P. fluorescens sobre varias cepas de B. thuringiensis y otros Bacilli in vitro se debe a la secreción de algún compuesto tóxico del tipo de los antibióticos y su producción es favorecida por temperaturas cercanas a 28 °C, pero disminuida por las cercanas a 37 °C. En cuanto a las condiciones nutricionales de los medios de cultivo también hay afectación antagónica, quizás por la relación entre el tipo de nutrientes y el balance carbono–nitrógeno disponible para las bacterias que cohabitan un espacio temporal. Respecto a las condiciones ambientales, parece que B. thuringiensis en el suelo tiende a desarrollarse poco, o más bien sólo sobrevive a las condiciones adversas. Esto lo logra cuando alcanza a esporular y su contacto es bajo con altas poblaciones de bacterias antagónicas o sus metabolitos secundarios.
AGRADECIMIENTOS
Al CONACyT por la beca de Doctorado en Ciencias Ambientales con número de registro 143058 y los recursos otorgados para la realización del proyecto SEP–2004–C01–47120.
LITERATURA CITADA
Aguilar H., L., y J. Ibarra. 1995. Selección de cepas mexicanas de Bacillus sphaericus con actividad larvicida contra mosquitos vectores (Díptera: Culicidae). Vedalia 3: 3–9. [ Links ]
Budde, I.P, and M. S. Ullrich. 2000. Interactions ofPseudomonas syringae pv. glycinea with host and nonhost plants in relation to temperature and phytotoxin synthesis. Mol. Plant Microbe Interaction 13: 951–961. [ Links ]
Cafferkey, M. T., K. McClean and M. E. Drumm. 1989. Production of bacteriocin–like antagonism by clinical isolates of Yersinia enterocolitica. J. Clin. Microbiol. 27: 677–680. [ Links ]
Crickmore, N., R. D. Zeigler, J. Feitelson, E. Schnepf, J. Van Rie, D. Lereclus, J. Baum, and H. D. Dean. 1998. Revision of the nomenclature for the Bacillus thuringiensis pesticidal crystal proteins. Microbiol. Mol. Biol. Rev. 62: 807–813. [ Links ]
De Maagd, R. A., A. Bravo, and N. Crickmore. 2001. How Bacillus thuringiensis has evolved specific toxins to colonize the insect world. Trends in Genetics 17: 193–199. [ Links ]
Duffy, B. K., and G. Défago. 1999. Environmental factors modulating antibiotic and siderophore byosinthesis by Pseudomonas fluorescens Biocontrol strains. Appl. Environ. Microbiol. 65: 2429–2438. [ Links ]
Dulmage, H. T. 1970. Insecticidal activity of HD–1, a new isolate of Bacillus thuringiensis var. alesti. J. Invertebr. Path. 15:232–39. [ Links ]
Firn, R. D., and C. G. Jones. 2000. The evolution of secondary metabolism —a unifying model. Mol. Microbiol, 37: 989–994. [ Links ]
Karlovsky, P. 2008. Secondary metabolites in soil ecology. In: Karlovsky, P. (ed) .Soil biology secondary metabolites in soil ecology. Springer–Verlag–Heidelberg. pp: 1–17. [ Links ]
Kurstak, E. 1962. Donnees sur l'epizootie bacterienne naturelle provoguee par un Bacillus du type Bacillus thuringiensis sur Ephestia kuhniella Zeller. Entomophaga Mem. Hors Ser. 2: 245–247. [ Links ]
Martin, W., and A. Phillis. 1994. An iconoclastic view of Bacillus thuringiensis ecology. American Entomologist, pp: 85–90. [ Links ]
Meadows, M. P. 1993. Bacillus thuringiensis in the environment: ecology and risk assessment. In: Enwiwistle, P. R, J. S Cory, M. J. Bailey, and S. Higgs (eds). Bacillus thuringiensis, an environmental biopesticide: Theory and Practice. Wiley, New York, N.Y. pp: 193–220. [ Links ]
Nielsen, M. N., J. Sorensen, J. Fels, and H. C Pedersen. 1998. Secondary metabolite and endochitinase dependent antagonism toward plant–pathogenic microfungi of Pseudomonas fluorescens isolates from sugar beet rhizosphere. Appl. Environ. Microbiol. 64: 3563–3569. [ Links ]
Notz, R., M. Maurhofer, H. Dubach, and G. Défago. 2002. Fusaric acid–producing strains of Fusarium oxysporum alter 2,4–diacetylphloroglucinol biosynthetic gene expression in Pseudomonas fluorescens CHAO in vitro and in the rhizosphere of wheat. Appl, Environ. Microbiol. 68: 2229–2235. [ Links ]
Parret, A. H., and R. De Mot. 2002. Bacteria killing their own kind: novel bacteriocins of Pseudomonas and other c–proteobacteria. Trends Microbiol. 10: 107–112. [ Links ]
Petras, F. S., and E. L. Casida. 1985. Survival of Bacillus thuringiensis spores in soil. Appl. Environ. Microbiol. 50: 1496–1501. [ Links ]
Riley, M. A., and J .E. Wertz. 2002. Bacteriocins: evolution, ecology, and application. Ann. Rev. Microbiol. 56: 117–137. [ Links ]
Rojas R., N. E., E. Sansinenea R., R. Marsch M., P. Sánchez A., y C. Vázquez C. 2005. Compuestos tóxicos de Pseudomonas fluorescens y su papel como agente de control biológico contra microorganismos de suelo. In: Aragón, G. A., J. F. López O., y A. M. Tapia R. (eds). Manejo agroecológico de sistemas. Benemérita Universidad Autónoma de Puebla, pp: 175–187. [ Links ]
Sibide, M., S. Messier, S. Lariviere, M. Gottschalk, and K. R Mittal. 1993. Detection of Actinobacillus pleuropneumoniae in porcine upper respiratory tract as a complement to serological tests. Can. J. Vet. Res. 57: 204–208. [ Links ]
Validov, S., O. Mavrodi, L. De La Fuente, A. Boronin, D. Weller, L. Thomashow, and D. Mavrodi. 2005. Antagonistic activity among 2,4–diacetylphloroglucinol–producing fluorescent Pseudomonas spp. FEMS Microbiol. Lett. 242: 249–256. [ Links ]
West, A. W, H. D. Burges, T. J. Dixon, and C. H. Wyborn. 1985. Survival of Bacillus thuringiensis and Bacillus cereus spore inocula in soil: effects of pH, moisture, nutrient availability and indigenous microorganisms. Soil Biol. Bioch. 17: 657–665. [ Links ]














